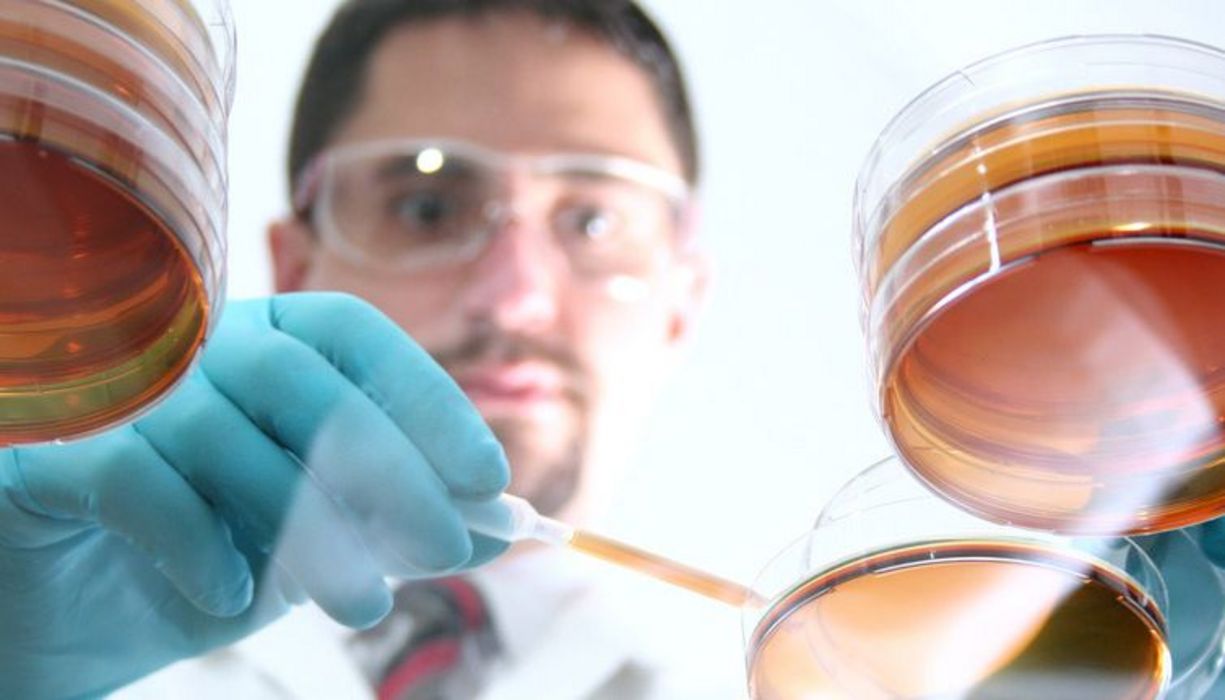

Unterschied zwischen Bakterien Viren und Pilzen Unterschied Zwischen 2020 Hauptunterchied. Ein Virus ist also ein Parasit.
Unterschied Zwischen Viren Bakterien Und Pilzen - Spaß für meinen eigenen Blog, bei dieser Gelegenheit werde ich Ihnen im Zusammenhang mit erklären Unterschied Zwischen Viren Bakterien Und Pilzen. Also, wenn Sie großartige Aufnahmen machen möchten Unterschied Zwischen Viren Bakterien Und Pilzen, Klicken Sie einfach auf das Speichersymbol, um das Foto auf Ihrem Computer zu speichern. Sie können heruntergeladen werden. Wenn Sie möchten und möchten, klicken Sie im Beitrag auf "Logo speichern". Der Download erfolgt direkt auf Ihren Heimcomputer.
Unterschied Zwischen Viren Bakterien Und Pilzen ist eine wichtige Information, die von Fotos und HD-Bildern begleitet wird, die von allen Websites der Welt stammen. Laden Sie dieses Bild kostenlos in High Definition-Auflösung mit der unten stehenden Option "Download-Schaltfläche" herunter. Wenn Sie nicht die genaue Auflösung finden, nach der Sie suchen, wählen Sie Original oder eine höhere Auflösung. Sie können diese Seite auch einfach speichern, sodass Sie sie jederzeit anzeigen können.
Hier sind Sie auf unserer Website, Artikel oben, veröffentlicht von Babang Tampan. Hoffe du mag bleibe genau hier. Für die meisten Upgrades und Neueste Nachrichten zum folgenden Foto folgen Sie uns bitte auf Twitter, Pfad, Instagram, oder Sie markieren diese Seite auf Lesezeichen Bereich, Wir versuchen Ihnen up grade regelmäßig mit frisch und neu Bilder, wie dein Suchen und finde das Perfekte für dich. Heute Wir sind erfreut, anzukündigen dass wir gefunden ein sehr interessanter Thema, der besprochen, viele Individuen versuchen Einzelheiten von zu finden, und definitiv einer von ihnen bist du, nicht wahr?
 Der Unterschied Zwischen Bakterien Und Viren Apotheken Umschau
Der Unterschied Zwischen Bakterien Und Viren Apotheken Umschau
Die Zellen von Pilzen haben Kerne die die Chromosomen und andere Organellen wie Mitochondrien und Ribosomen enthalten.

Unterschied zwischen viren bakterien und pilzen. Der Hauptunterschied besteht darin dass sie eine voellig unterschiedliche Zellzusammensetzung haben. Bakterien haben keine Hyphen Pilze haben Hyphen und alle Hyphen bilden zusammen das Myzel. Nabeel Hamzas Antwort auf Was ist der Unterschied zwischen Bakterien und Viren.
Bakterien koennen bis zu hundert Mal groesser sein als Viren. Den menschlichen Koerper dessen Zellen ihnen bei der Reproduktion. Unterschied viren und bakterien wikipedia.
Was ist der Unterschied zwischen Bakterien und Pilzen. Bakterien sind Einzeller haben einen Stoffwechsel und koennen sich selbst reproduzieren fortpflanzenViren bestehen nur aus einer Eiweisshuelle in der sie ihre Erbsubstanz aufbewahren. Im Gegensatz zu Bakterien verfuegen Viren ueber keinen Zellkern und koennen sich auch nicht selbst vermehren wie es Bakterien durch Zellteilung tun.
Sticky Post By On 4. Bakterien haben einen Durchmesser von bis zu einem Mikrometer und sind damit im Durchschnitt immerhin bis zu hundert Mal groesser als Viren die 20 bis 300 Nanometer gross sein koennen. Ein Unterschied zwischen Viren und Bakterien liegt in der Groesse.
Sie koennen jedoch auch Verletzungen verursachen und die Koerperfunktionen bis zur Entstehung von Krankheiten beeintraechtigen. Unter einem Lichtmikroskop kann man Bakterien also noch gut erkennen waehrend man fuer Viren schon ein Elektronenmikroskop benoetigt. Ie replizieren ich aexuell.
Hier sind einige signifikante Unterschiede zwischen Bakterien und Pilzen da sie eine wichtige Rolle in der Oekologie spielen. Hier sind einige signifikante Unterschiede zwischen Bakterien und Pilzen da sie eine wichtige Rolle in der Oekologie spielen. Bakterien und Viren sind Erreger die den menschlichen Organismus oder andere Organismen befallen koennen und so eine Infektion ausloesen koennen.
Pilze sind mehrzellige eukaryotische Organismen waehrend Bakterien einzellige Prokaryoten sind. Bakterien ind einzellige und prokaryotiche Organimen. Bakterien nehmen Naehrstoffe Kohlenhydrate Proteine und Fette auf um zu ueberleben wachsen und sich zu repdroduzieren.
Sie dringen in Wirtszellen ein und vermehren sich dort. Bakterien sind deutlich groesser als Viren. Sobald der Virus es geschafft hat in die Zelle einzudringen wird sein Erbgut in der Zelle aktiv und veranlasst die Wirtszelle neue Viren zu produzieren.
Falls das nicht gelingt koennen Medikamente bzw. Bestimmte Wirkstoffe darin manche Erreger gezielt bekaempfen oder wenigstens deren. Viren hingegen koennen sich nicht selbststaendig vermehren.
Das wird dann in aller Regel vom Immunsystem des Koerpers bekaempft. Clemens Fahrig Chefarzt und Aerztlicher Direktor der Klinik fuer Innere Medizin am Evangelischen Krankenhaus Hubertus in Berlin. Was ist der Unterschied zwischen Bakterien und Pilzen.
Sie benoetigen Zellen als Wirte. Bakterien bestehen im Gegensatz zu Viren aus einer Zelle. Bakterien haben keine Hyphen Pilze haben Hyphen und alle Hyphen bilden zusammen das Myzel.
Bakterien haben keinen Kern mit Kernmembran aber Pilze haben. Der groesste Unterschied zwischen Bakterien und Viren hinsichtlich der Reproduktion liegt darin dass Bakterien sich wie auch menschliche Zellen durch Zellteilung vermehren. Bakterien und Viren sind am einfachsten an ihrer Groesse zu unterscheiden.
Die chemischen und strukturellen Unterschiede zwischen ihren Zellwaenden sind jedoch ein Grund dafuer dass Antibiotika die gegen Bakterien wirksam sind gegen Pilze unwirksam sind und umgekehrt. Bakterien sind nicht wie der Virus auf einen Wirt angewiesen. Viren benoetigen dazu eine Zelle ihres Wirts.
Die Zellwaende von Bakterien und Pilzen schuetzen sie vor der Umwelt und geben ihnen unter anderem Form. Corona-Viren sind im Gegensatz zu Bakterien keine Lebewesen. Der Hauptunterschied besteht darin dass sie einen voellig anderen Zellaufbau haben.
Sie benoetigen eine andere Zelle eine sogenannte Wirtszelle um zu leben und sich vermehren zu koennen. Unterschied zwischen Bakterien und Viren. Der Hauptunterschied zwischen Bakterien und Pilzen ist dass Bakterien Prokaryoten sind waehrend Pilze Eukaryoten sind.
Viren koennen nicht eigenstaendig leben weil sie keinen eigenen Stoffwechsel zur Energiegewinnung haben. Bakterien sind bis zu hundert mal groesser als Viren erklaert Dr. E haengt von der Art der Bakterien ab.
Bakterien haben keinen Kern mit Kernmembran aber Pilze haben. Daher benoetigen sie einen Wirt wie zB. Bakterien sind groesser als Viren.
Der Hauptunterschied zwischen Bakterien und Pilzen ist dass Bakterien Prokaryoten sind waehrend Pilze Eukaryoten sind. Waehrend Viren so winzig sind dass man sie nur unter einem sogenannten Elektronenmikroskop sehen kann sind Bakterien bis zu 100-mal groesser und lassen sich unter einem normalen Lichtmikroskop erkennen. Bakterien werden als prokaryotische Organismen bezeichnet was bedeutet dass sie keinen Zellkern besitzen waehrend Pilze.
Sie nehmen keine Naehrstoffe auf. Pilze ernaehren sich normalerwesie von Einfachzuckern Zweifachzuckern und Aminosaeuren. Ie koennen owohl chaedlich al auch vorteilhaft ein.
Unterschiede Zwischen Viren Bakterien Und Pilzen
 Viren Bakterien Unterschied Gemeinsamkeiten
Viren Bakterien Unterschied Gemeinsamkeiten
 Was Ist Der Unterschied Zwischen Bakterien Und Viren Coopzeitung
Was Ist Der Unterschied Zwischen Bakterien Und Viren Coopzeitung
 Mikroorganismen Zuordnungsaktivitat Unterrichtsmaterial Im Fach Biologie Mikroorganismen Lernen Vokabeln Lernen
Mikroorganismen Zuordnungsaktivitat Unterrichtsmaterial Im Fach Biologie Mikroorganismen Lernen Vokabeln Lernen
 Basics Viren Bakterien Einzeller Bloodnacid
Basics Viren Bakterien Einzeller Bloodnacid
 5 Viren Erkaltung Klasseklingler Ch
5 Viren Erkaltung Klasseklingler Ch
 Phytotab Tabellen Der Kategorie Pilze
Phytotab Tabellen Der Kategorie Pilze
 Unterschied Zwischen Bakterien Viren Und Pilze
Unterschied Zwischen Bakterien Viren Und Pilze
 Helfer Oder Killer So Machtig Sind Bakterien Viren Pilze Swr Wissen
Helfer Oder Killer So Machtig Sind Bakterien Viren Pilze Swr Wissen
Was Ist Der Unterschied Zwischen Bazillen Viren Co Aponet De
Was Ist Der Unterschied Zwischen Bazillen Viren Co Aponet De
 Der Unterschied Zwischen Bakterien Und Viren Quarks De
Der Unterschied Zwischen Bakterien Und Viren Quarks De
 Zoonosen Zwischen Mensch Und Tier Ubertragbare Krankheiten Die Schweizer Plattform Fur Kostenlose Tierinserate
Zoonosen Zwischen Mensch Und Tier Ubertragbare Krankheiten Die Schweizer Plattform Fur Kostenlose Tierinserate
 Unterschied Tiere Pflanzen Bakterien U Pilze Und Die Zellorganellen Pdf Free Download
Unterschied Tiere Pflanzen Bakterien U Pilze Und Die Zellorganellen Pdf Free Download
 Kinderbucher Uber Bakterien Viren Und Pilze Kinderbuch Detektive Kinderbucher Bakterien Mikrobiologie
Kinderbucher Uber Bakterien Viren Und Pilze Kinderbuch Detektive Kinderbucher Bakterien Mikrobiologie